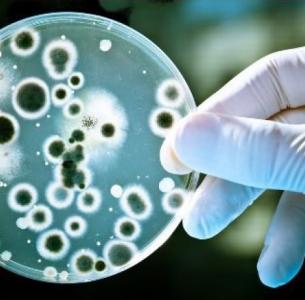

PARODONTITE: Bientôt un vaccin contre P. gingivalis ?
1 adulte sur 3 aura une parodontite au cours de la vie. Ces scientifiques de Melbourne publient des données probantes sur le premier candidat vaccin thérapeutique dentaire au monde ! Et les essais de vaccination thérapeutique contre la parodontite pourraient débuter dès 2018…Une perspective très prometteuse, présentée dans la revue spécialisée NPJ Vaccines, alors que les traitements traditionnels de la parodontite, dont la chirurgie et les antibiotiques, ne permettent pas d'éliminer le risque de récidive.
La parodontite affecte un adulte 1 adulte sur 3 environ, plus de 50% des plus de 65 ans. Cette infection chronique des gencives est associée au diabète, aux maladies cardiaques, à la polyarthrite rhumatoïde, à la démence et à certains cancers. En détruisant les tissus de la gencive et les tissus osseux, la maladie chronique entraîne la perte des dents.
Ce vaccin développé à l'issue de 15 années de recherche par des scientifiques de Melbourne, pourrait éliminer ou réduire la nécessité de chirurgie et d'antibiotiques. Les essais cliniques sur les patients atteints de parodontite pourraient commencer dès 2018. Ici les chercheurs publient de premiers résultats prometteurs d'efficacité du vaccin.
Le vaccin cible les enzymes produites par la bactérie Porphyromonas gingivalis, pour déclencher une réponse immunitaire qui produit des anticorps qui neutralisent les toxines destructrices du pathogène. P. gingivalis est connu comme un pathogène clé, en raison de sa capacité à détruire l'équilibre des micro-organismes de la plaque dentaire, ce qui favorise le développement de maladies buccodentaires. De récentes études ont désigné la bactérie avec Treponema denticola and Tannerella forsythia comme associée très fortement à la parodontite, représentant à elle-seule jusqu'à 15% de la charge bactérienne. Le vaccin conçu pour empêcher bien sûr la destruction des tissus chez les patients hébergeant P. gingivalis, se montre ici capable, sur la souris modèle de parodontite, d'empêcher le rétablissement de la bactérie dans la plaque dentaire après un nettoyage chirurgical de la gencive et un traitement antibiotique.
Si ces premiers résultats étaient confirmés, ce vaccin pourrait permettre d'améliorer la qualité de vie de millions de personnes.
01 December 2016 doi:10.1038/npjvaccines.2016.22 A therapeutic Porphyromonas gingivalis gingipain vaccine induces neutralising IgG1 antibodies that protect against experimental periodontitis (Visuel Eurodent)
Plus d'études sur la Parodontite
